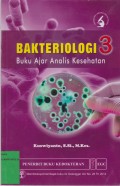
image

Buku Ajar Dasar Kesehatan dan Keselamatan Kerja (K3)
- Edisi
- -
- ISBN/ISSN
- 978-623-10-0596-0
- Deskripsi Fisik
- vi; 85 hlm; 15x23 cm
- Judul Seri
- -
- No. Panggil
- 613.6 DAV B
- Edisi
- -
- ISBN/ISSN
- 978-623-10-0596-0
- Deskripsi Fisik
- vi; 85 hlm; 15x23 cm
- Judul Seri
- -
- No. Panggil
- 613.6 DAV B
Hasil Pencarian
Ditemukan 1 dari pencarian Anda melalui kata kunci: Pengarang : David Kusmawan
Permintaan membutuhkan 0.00064 detik untuk selesai

Karya Umum
Karya Umum  Filsafat
Filsafat  Agama
Agama  Ilmu-ilmu Sosial
Ilmu-ilmu Sosial  Bahasa
Bahasa  Ilmu-ilmu Murni
Ilmu-ilmu Murni  Ilmu-ilmu Terapan
Ilmu-ilmu Terapan  Kesenian, Hiburan, dan Olahraga
Kesenian, Hiburan, dan Olahraga  Kesusastraan
Kesusastraan  Geografi dan Sejarah
Geografi dan Sejarah